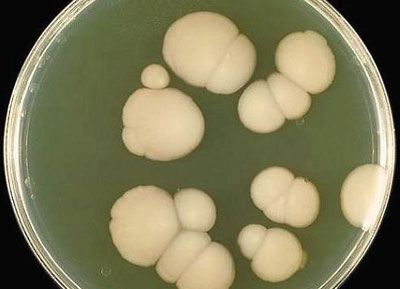

Генітальний кандидоз - одне з найбільш часто зустрічаються захворювань серед жіночої половини населення, однак подібний недуга може вражати і чоловіків і навіть дітей.
Збудником такої патології служать дріжджові гриби роду Кандида, які викликають запалення піхви і вульви.
Причини і симптоми
Основним фактором виникнення даного захворювання є грибок. Генітальний кандидоз часто приносить жінці масу дискомфорту, тоді як у чоловіків може практично ніяк себе не проявляти.
Дріжджоподібних грибок Кандида є умовно-патогенних, і він присутній в нормі в роті, на оболонках товстого кишечника і піхви.
При належній роботі імунної системи проблем не виникає. Але якщо захисні сили організму знижуються при певних умовах, то грибок починає активно розмножуватися і стає вже захворюванням, яке потребує лікування.
Генітальний кандидоз може бути спровокований рядом причин:
- зниженням імунітету,
- наявністю гострих інфекційних захворювань,
- післяопераційним періодом,
- прийомом антибіотиків,
- недотриманням гігієни зовнішніх статевих органів,
- частою зміною сексуальних партнерів,
- настанням вагітності,
- гормональними порушеннями,
- застосуванням оральних контрацептивів,
- зловживанням солодощами,
- дисбактеріозом кишечника.

Отже, причини виникнення подібного недуги досить різноманітні, але головним стимулятором розвитку хвороби є знижений імунітет. Генітальний кандидоз може проявлятися по-різному у чоловіків і жінок. Однак найбільш яскраво виражені ознаки у представниць прекрасної статі.
- Густі сирнистий виділення. Ця ознака допомагає відрізнити даний вид інфекції від інших захворювань. Виділення нагадують сирні грудочки, вони рясні, білі і з неприємним кислим запахом. У цьому випадку важливо не сплутати кандидоз із захворюваннями, що передаються статевим шляхом. Ті, в свою чергу, наприклад хламідіоз і трихомоніаз, характеризуються пінистими жовтуватими виділеннями з вираженим запахом риби.
- Сверблячка і печіння. Ближче до початку менструації ознаки посилюються. Сверблячка і печіння стають нестерпними, статеві органи запалюються.
- Болі при статевому контакті і при сечовипусканні. Якщо інфекція зачіпає уретру, то дискомфорт посилюється. Болі можуть виникати як під час статевого акту в області живота і геніталій, так і при сечовипусканні, особливо коли вульва і вагінальна частина шийки матки вже значно гіперемійовані.
- Печіння і свербіж в геніталіях, а саме в області головки члена.
- Біль при статевому акті.
- Почервоніння і білястий наліт на голівці члена.
- Білі виділення при акті сечовипускання.
При підозрі на кандидоз необхідно звернутися до лікаря, так як дане захворювання може поєднуватися з іншими інфекціями, що передаються статевим шляхом.
Терапія генітального кандидозу не представляє труднощі, так як на сьогоднішній день існує цілий ряд препаратів, спрямованих на придушення грибкової інфекції. Часом досить одноразового прийому для того, щоб позбутися від прояву неприємних симптомів.
Для лікування генітального кандидозу використовуються місцеві засоби і медикаменти, які всмоктуються через шлунково-кишковий тракт. Щоб досягти найкращих результатів, необхідно поєднувати 2 види терапії. Різноманітність препаратів і свічок допомагає підібрати підходящий в конкретному випадку спосіб.
Виділяють наступні види медикаментів, спрямованих на усунення симптомів і лікування інфекції, викликаної дріжджоподібними грибками:
- Таблетки і капсули: Мікомакс, Пімафуцин, Дифлюкан, Микосист, Флюкостат.
- Свічки для введення в піхву: Клотримазол, Полижинакс, Залаїн, Гексикон, Тержинан.

Не варто обходити стороною і стан кишечника, адже при наявності дисбактеріозу ризик виникнення кандидозу зростає. Застосовуються препарати, до складу яких входить клітковина, а також кошти, що сприяють росту корисної мікрофлори.
Під час лікування генітального кандидозу потрібно відмовитися від солодощів і нормалізувати раціон, включаючи більше свіжих овочів, здатних доповнити організм корисною клітковиною. Якщо подібне захворювання виникає занадто часто, то потрібно провести ряд діагностичних досліджень і виявити основну патологію, яка провокує такий процес. У ряді випадків позбутися від генітального кандидозу не складає праця.
Існує лікування і методами народної медицини, наприклад спринцеванием содою. Однак такий спосіб може завдати шкоди нормальної мікрофлори піхви, що згодом здатне спровокувати дисбактеріоз. Перш ніж приступати до того чи іншого методу терапії, слід проконсультуватися з лікарем.